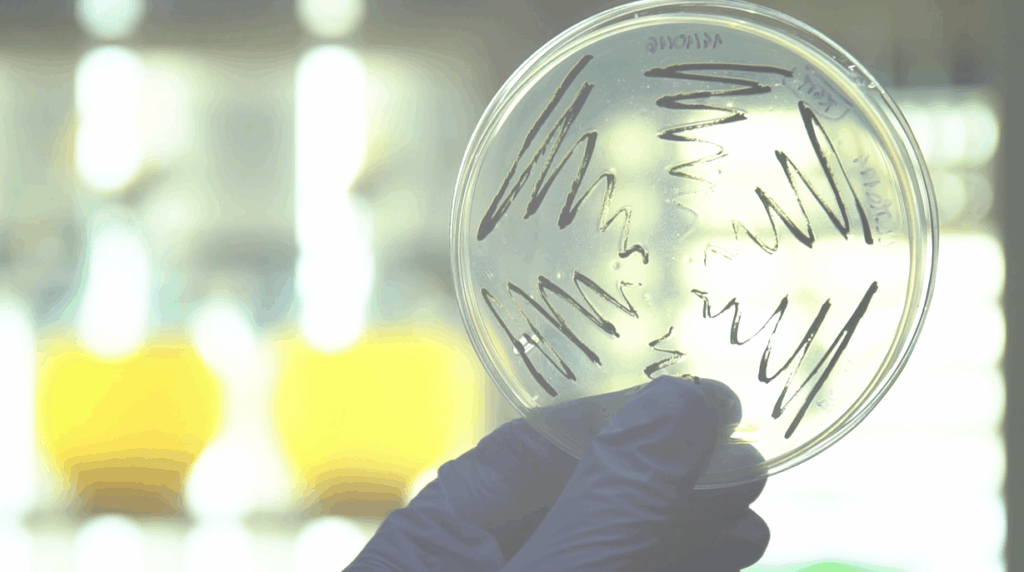

About Us
What is the project MULTIPLY about ?
MULTIPLY is a Horizon Europe-funded project focused on scaling up the production of sustainable microalgae-derived ingredients for a variety of bio-based industries. By optimizing cultivation techniques and biorefining processes, the project aims to make microalgae a cost-effective and scalable feedstock, overcoming existing technological barriers that have limited its widespread use in Europe.
Led by A4F ALGA FUEL SA, the project brings together 17 partners from across Europe, including industry leaders, technology developers, and research institutes. The consortium is committed to advancing microalgae cultivation and processing, deploying innovative digital tools, and integrating circular economy principles to reduce resource use and environmental impact.
MULTIPLY will develop 10 improved products from 5 microalgae species, addressing market demands across sectors like food, feed, biomaterials, lubricants, and cosmetics. Running from June 2025 to May 2029, the project is dedicated to microalgae powering a circular future, advancing the role of algae in a sustainable, circular economy across Europe.

Overall aim of the MULTIPLY project
MULTIPLY aims to demonstrate the scalability and economic viability of microalgae cultivation and biorefining processes for sustainable, bio-based products. By developing efficient, circular, and innovative technologies, the project seeks to reduce resource consumption and environmental impact, positioning microalgae as a key ingredient in the food, feed, biomaterials, lubricants, and cosmetics sectors. Ultimately, MULTIPLY aims to accelerate the growth of a sustainable, circular microalgae industry in Europe, contributing to a green, carbon-neutral economy.
Objective 1
Objective 2
Objective 3
Objective 4
Objective 5
Stay up to date
Suscribe to the MULTIPLY newsletter to stay updated with project progress.
